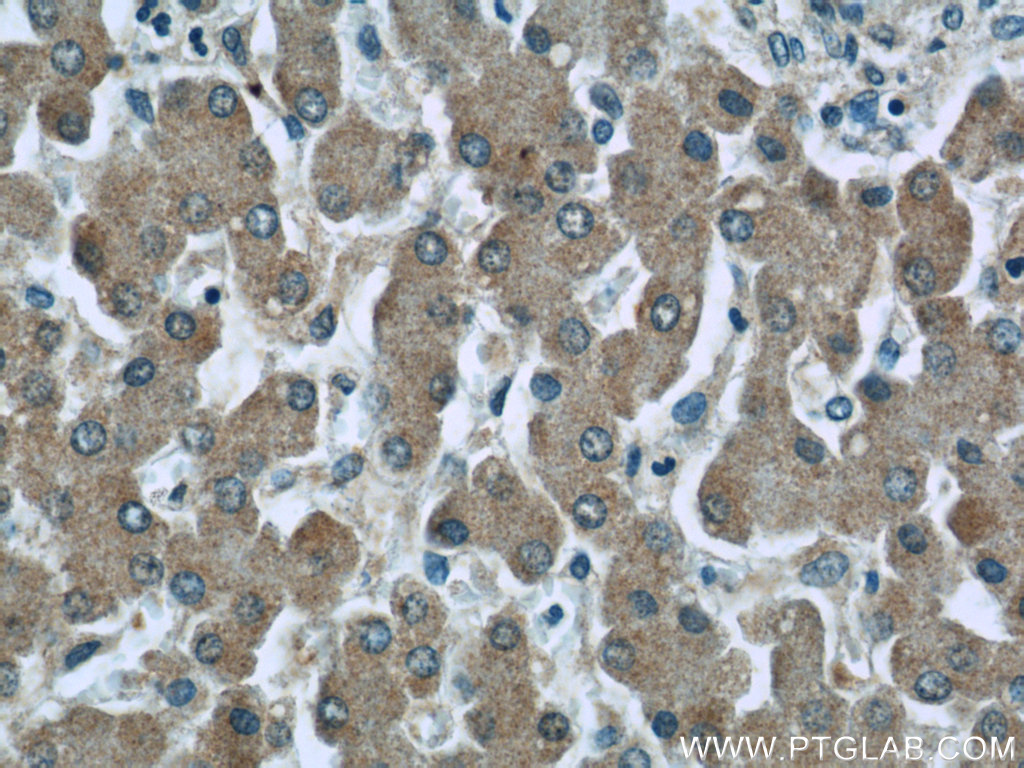

验证数据展示
产品信息
66157-1-PBS targets C3/C3b/C3c in WB, IHC, IF/ICC, ELISA applications and shows reactivity with human, mouse samples.
| 经测试应用 | WB, IHC, IF/ICC, ELISA Application Description |
| 经测试反应性 | human, mouse |
| 免疫原 |
CatNo: Ag15955 Product name: Recombinant human C3 protein Source: e coli.-derived, PET28a Tag: 6*His Domain: 1314-1663 aa of BC150179 Sequence: ESASLLRSEETKENEGFTVTAEGKGQGTLSVVTMYHAKAKDQLTCNKFDLKVTIKPAPETEKRPQDAKNTMILEICTRYRGDQDATMSILDISMMTGFAPDTDDLKQLANGVDRYISKYELDKAFSDRNTLIIYLDKVSHSEDDCLAFKVHQYFNVELIQPGAVKVYAYYNLEESCTRFYHPEKEDGKLNKLCRDELCRCAEENCFIQKSDDKVTLEERLDKACEPGVDYVYKTRLVKVQLSNDFDEYIMAIEQTIKSGSDEVQVGQQRTFISPIKCREALKLEEKKHYLMWGLSSDFWGEKPNLSYIIGKDTWVEHWPEEDECQDEENQKQCQDLGAFTESMVVFGCPN 种属同源性预测 |
| 宿主/亚型 | Mouse / IgG1 |
| 抗体类别 | Monoclonal |
| 产品类型 | Antibody |
| 全称 | complement component 3 |
| 别名 | C3, C3/C3a, C3 and PZP-like alpha-2-macroglobulin domain-containing protein 1, ASP, ARMD9 |
| 计算分子量 | 1663 aa, 187 kDa |
| 观测分子量 | 115 kDa |
| GenBank蛋白编号 | BC150179 |
| 基因名称 | C3 |
| Gene ID (NCBI) | 718 |
| RRID | AB_2881553 |
| 偶联类型 | Unconjugated |
| 形式 | Liquid |
| 纯化方式 | Protein G purification |
| UNIPROT ID | P01024 |
| 储存缓冲液 | PBS only, pH 7.3. |
| 储存条件 | Store at -80°C. The product is shipped with ice packs. Upon receipt, store it immediately at -80°C |
背景介绍
The complement system is an important effector that bridges the innate and adaptive immune systems (PMID: 20010915). The third component of complement, C3, plays a central role in the activation of the complement system. Its processing by C3 convertase is the central reaction in both classical and alternative complement pathways (PMID: 11414361). Human C3, composed of α and β chains (115 and 75 kDa, respectively), is cleaved into C3a and C3b by C3 convertase. C3b is further cleaved into iC3b, C3c, C3dg and C3f. This antibody raised against 1314-1663 aa of human C3 protein recognizes the C3 alpha chain, C3b alpha' chain, and C3c alpha' chain fragment 2.